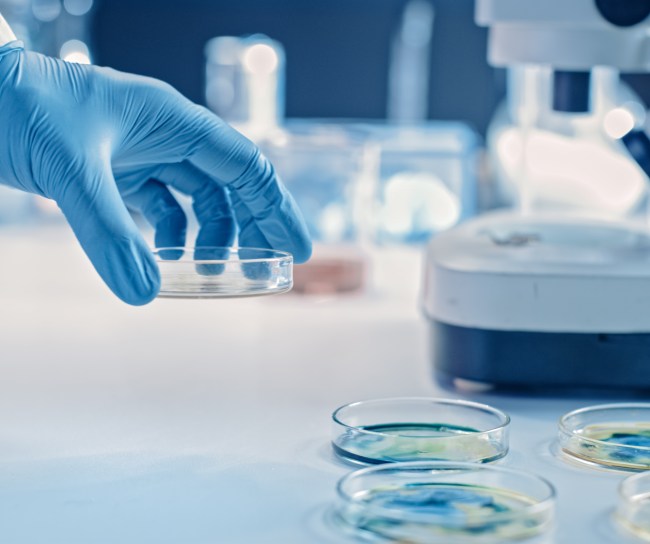

Forschung für die Menschheit
Die Gesundheit der Menschen ist unser Antrieb. Wir entwickeln innovative Medikamente und Impfstoffe, um immer mehr Menschen weltweit helfen zu können.
Unsere Kompetenz
Als forschendes biopharmazeutisches Unternehmen tragen wir seit mehr als 130 Jahren dazu bei, dass immer mehr Krankheiten heilbar und besser behandelbar werden. Dabei lassen wir uns von der Wissenschaft leiten. Wir treiben den medizinischen Fortschritt voran, um Erkrankungen zu verhindern und Therapieerfolge zu erhöhen. Damit gewinnen Patient:innen sowohl Lebenszeit als auch Lebensqualität.

„Für viele Erkrankungen und gesundheitliche Beschwerden, unter denen Patientinnen und Patienten leiden, können Behandlungsergebnisse und Gesundheitsversorgung noch verbessert werden. Mit unserer Forschung wollen wir dazu beitragen, für so viele Menschen wie möglich einen Unterschied machen – in Deutschland und auf der ganzen Welt.“
Kevin Peters, Geschäftsführer MSD in Deutschland
Forschung in Deutschland
Euro Ausgaben für Forschung & Entwicklung im Jahr 2022
laufende klinische Studien
Innovation – Erfahrung – Austausch
Unsere Schwerpunkte liegen in der Onkologie, in der Entwicklung neuer Impfstoffe und in der Forschung im Bereich der Infektionskrankheiten. Als eines von wenigen Pharmaunternehmen weltweit entwickeln wir neue Antibiotika, damit wir auch in Zukunft wirkungsvolle Medikamente gegen resistente Keime zur Verfügung haben. Wir forschen auch in anderen Fachrichtungen, u. a. an Herz-Kreislauf-Erkrankungen oder in der Immunologie. Dabei verlassen wir uns nicht nur auf unsere lange Erfahrung, sondern nutzen für unsere Forschung auch moderne Technologien wie Künstliche Intelligenz und Data Management. Mit einem globalen Netzwerk von Patient:innen und Patientenvertreter:innen, Wissenschaftler:innen, Pharmaunternehmen und Politik stehen wir in regelmäßigem Wissensaustausch.

Unsere Überzeugung
Als Hersteller von Medikamenten und Impfstoffen sind wir uns unserer gesellschaftlichen Verantwortung bewusst. Wir setzen uns ein für einen bezahlbaren Zugang und eine faire Verteilung lebensrettender Medikamente. Bestimmte Impfstoffe, zum Beispiel gegen Ebola, bieten wir deshalb zum Selbstkostenpreis an. Wir leisten Aufklärungsarbeit zum Thema Impfen und arbeiten unermüdlich und gewissenhaft daran, damit mehr Krankheiten verhindert und besser therapiert werden können.
Zahlen & Fakten
-
1/4 unseres Umsatzes investieren wir in Forschung und Entwicklung.
-
2022 konnten wir Menschen in 76 % der Länder weltweit mit unseren Medikamenten und Impfstoffen helfen.
- Rund 40 verschiedene Arzneimittel und Impfstoffe von MSD sind aktuell in Deutschland verfügbar.
- Unsere Arzneimittel und Impfstoffe kommen weltweit zum Einsatz.
- Über 100 Arzneimittel und Impfstoffe von MSD sind aktuell in der Pipeline.
-
21.800 Mitarbeiter:innen von MSD arbeiten in der Forschung weltweit.